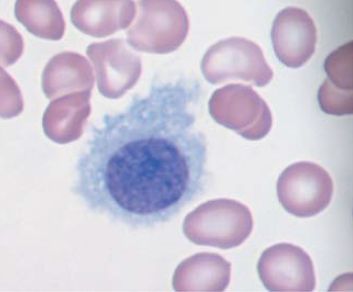

HCL:
Haarzell - Leukämie
Allgemeines
Epidemiologie
Prognose
Klinik
- Knochenmarkfibrose
- Splenomegalie
- Leukopenie
- z.T. Panzytopenie
- Monozytopenie
- Anisozytose
- niedrige Retikulozytenwerte.
Staging
Diagnostik
Morphologie
Molekularbiologie
Immun-Histochemie
- CD11c
- CD25
- Tartrat-resistente saure Phosphatase
- CD19
- CD20
- CD103
- CD5
- CD10
Therapie
Chemotherapie
- 7 x 24-Stunden-Dauerinfusion Leustatin® oder
- 5 Tage 2-stündige Infusion oder
- subkutane Injektion an 5 Tagen (Litak®)
Targettherapie
Ergebnisse
Teil von
